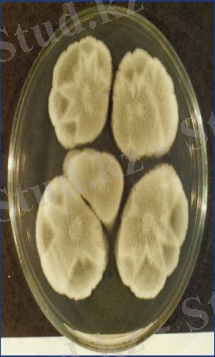
"Penicillium purpurogenum" on potato dextrose agar

Пенициллотоксикоз: қоздырғыштары, морфологиясы, токсиндері және алдын алу шаралары


Жоспар:
І Кіріспе
ІІ Негізгі бөлім
2. 1 Пенициллотоксикоздың қоздырғыштары, морфологиясы, өсіп-өнуі
2. 2 Пенициллотоксикоздың қоздырғыштарының төзімділігі, токсиндері
ІІІ Қорытынды
ІV Пайдаланылған әдебиеттер
І Кіріспе
Микотоксикоздар - саңырауқұлақтар бөлетін, токсинді метаболиттерден тұратын азықты жануарлар жеуден пайда болатын ауруларды айтады. Микотоксикоздар бүкіл үй жануарлары түрлерінде, жабайы аңдарда, құстар, балықтарда кездеседі және көптеген елдерде тіркелген.
Микотоксиндер деген саңырауқұлақтардың алмасу үрдістерінің нәтижесінде қалыптасатын улы өнімдер. Саңырауқұлақтардың өсуі және олардың токсиндерінің қалыптасуы сыртқы қоршаған факторларына байланысты, көбінесе температурадан және ылғалдықтан пайда болады. Микотоксикоздар жыл маусымына қарай пайда болады. Азық сапасын нашарлататын жағдайлар және оларды сақтау шарттарының бұзылуы саңырауқұлақтардың өсуін және токсиндерінің бөлінуін үдетеді. Саңырауқұлақтармен ластанған азықты рационге қосқан жағдайда малдың өсіп дамуы нашарлайды және өлуі көбейеді. Микотоксикоздар этиопатогенезінде ең маңызды микотоксиндер (грекше mykes-саңырауқұлақ және toxicon-у) . Токсинді метаболиттерді продуцирлейтін 250 микромицеттер тіркелген. Бір саңырауқұлақ бірнеше микотоксиндер бөлуі мүмкін. Қазіргі кезде метаболиттердің 100 токсиндері белгілі. Токсикалық әсерімен қатар олардың мутагендік, карциногендік, тератогендік қасиеттері де болады.
Ауыл шаруашылығы жануарларының улы микроскопиялык саңырауқұлақтармен зақымдалган жем-шөппен азықтануы ceбeптi пайда болатын ауру түрлері микотоксикоздар қатарына жатқызады. Осы аурулар тобына клавицепстоксикоз, эрготизм, жылқының дендродохиотоксикозы, стахиботриотоксикоз, фузариотоксикоз, Kөгеріп кеткен өсімдік токсикоздары жатады. Микотоксикоздарды қоздыратын саңырауқұлактар көбіне жетілмегендер қатарына (fungi imferfecti) және қалталылар қатарына (Ascom ycetes) жатқызылады.
ІІ Негізгі бөлім
Пеницилл, пенициллиум (Penicillium) - зең саңырауқұлақтарының үлкен бір тобы. Пенициллдің 250-ге жуық түрі бар, топырақ арасында көп таралған (1г топырақта 1 Пеницилл), органикалық қалдықтарды ыдыратады. Пенициллдер антибиоктер алуда, сыр дайындауда пайдаланылады. Мұнымен қатар жеміс, ет сүт т. б. тағамдарды, орылған астық дақылдарын, шөпті, мал жемін бұзып үлкен зиян да келтіреді. Пенициллдің көптеген түрі - адамның, малдың тері аурулары, тыныс алу органдары, ішкі органдары аурулары қоздырғышы.
Пеницилл споралардың көмегімен және вегетативті жолмен көбейе алады. Бүршік жару барысында жасушада аналық жасуша төмпешік - бүршік туындайды, ол өседі және белгіленген өлшемдерге жетісімен, аналық жасушадан бөлінеді. Жайлы шарттарда бүршік жару үдерісі ашамамен 2 сағатқа созылады. Кейбір ашытқыларда еншілес жасушалары аналықтан бөлінбейді, жалған мицелий түзе отырып, қосылған болып қалады. Жасушада 2-8 аскоспоралар туындайды, олар жетілгенде әлсіреген гаплоидті ұрпақ бере отырып, бүршік жарып көбеюін жалғастыруы мүмкін. Екі гаплоидті аскоспоралардың қосылу нәтижесінде кейіннен қалыпты ұрпақ беретін, диплоидті зигота түзіледі.
Зең саңырауқұлақтарын «қысылған тамшы» әдісімен препарат дайындап, зерттейді. Ол үшін материалды препарат инесінің көмегімен зат шынысының бетіндегі бір тамшы физиологиялық ерітіндіде таратады.
2. 1 Пенициллотоксикоздың қоздырғыштары, морфологиясы, өсіп-өнуі
Пенициллотоксикоздың қоздырғыштары. Пенициллотоксикоз - малдың Penicillium туысы грибтердің токсиндік заттарымен улануынан болатын ауру. АҚШ-та (1962) Penicillium грибімен зақымдалуы ceбeптi шошқаның жаппай ауруға ұшырауы орын алады. Penicillium rubrum және P. purpurogenum грибтерімен зақымдалған дәнді жеген балапандар микотоксикозға шалдығады. Penicillium туысы аскомицеттер класына жатады. Типтік түpi - Penicillium glaucum, оның 30-дан астам түpi адам мен жануарлардың ауруын қоздырады. Грибтің бұл тұқымы табиғатта кең тараған. Оны жем-шөпке, сүт өнімдерінен, ылғалды заттардан ecкi теріден, сиядан, вареньеден табуға болады.

 Penicillium glaucum
Penicillium glaucum
 Penicillium rubrum
Penicillium rubrum
P. purpurogenum
P. purpurogenum
Морфологиясы. Пенициллотоксикоз қоздырғыштарының мынадай элементтері болады: септикалық мицeлийлepi (2 - 8 мкм), жыныстық денешіктері ұзынша келген бipнеше кондиеносецтардан-стеригмалардан құралады. Стеригмалардың пішіні аша тәрізді, сондықтан грибтің жыныстық денешігінің формасы шашақ сияқты болады.
Өсіп-өнуі. Грибтер ауасы бар жерде өседі Сабуро немесе Чапек агарында, 18-25°С температурада, Петри тостағанына кұйылған қан агарында (pH 6, 0-7, 0) өсіріледі. Грибтің культурасы ортаның беткі жағына жиналатын жасыл түсті қабық-дақ.
2. 2 Пенициллотоксикоздың қоздырғыштарының төзімділігі, токсиндері
Tөзiмдiлiгi. Көптеген пенициллдердің токсиндерін температура (180°С) және ультракүлгін сәуле ыдырата алмайды. Пенициллдердiң токсиндерімен зарарланған жем-шеп буландыру арқылы зарарсыздандырылмайды (жем-шөптің улылығының дәрежесі болар-болмас кемиді), токсинді заттарды сілтілер мен қышқыл ыдыратпайды.
Токсиндері. Таза күйінде мынадай токсиндер алынды: ругулозин, исландин, рутроскарин, патулин. Олар ipi қарада, шошқада, құста қабыну процесін туғызады, тканьдерді өлieттeндipeдi. Улы антибиотик патулин тканьдер культурасының клеткаларына әсер eтіп, қандағы лимфоциттердің санын кемітеді. Біршама ферменттердің жұмысын тежейді. Ақ тышқандардың күре тамырына массасының 10 - 15мг/кг-на ЛД50 патулин енгізеді. Tepi астына жібергенде 25-35мг/кг, iшкe жібергенде 35мг/кг есебіне шағып жібереді. Оның антидиуретикалық қасиетте болады, қан тамырларының өткізгіштігін арттырады, жараның жазылуын тежейді.

 Патулин
Патулин
Диагноз қою. Зақымдалған жем-шөптің улылығын гуппи балығында және үй қоянына тepi биосынамасын жасау арқылы анықтайды. Қажет болған жағдайда грибтің таза культурасын алады. Микологиялық зерттеу 10 күннен 25 күнге дейін созылады. Пенициллотоксикоздың алдын алу және емдеу үшін қажетті биопрепараттар жасалмаған.
ІІІ Қорытынды
... жалғасы- Іс жүргізу
- Автоматтандыру, Техника
- Алғашқы әскери дайындық
- Астрономия
- Ауыл шаруашылығы
- Банк ісі
- Бизнесті бағалау
- Биология
- Бухгалтерлік іс
- Валеология
- Ветеринария
- География
- Геология, Геофизика, Геодезия
- Дін
- Ет, сүт, шарап өнімдері
- Жалпы тарих
- Жер кадастрі, Жылжымайтын мүлік
- Журналистика
- Информатика
- Кеден ісі
- Маркетинг
- Математика, Геометрия
- Медицина
- Мемлекеттік басқару
- Менеджмент
- Мұнай, Газ
- Мұрағат ісі
- Мәдениеттану
- ОБЖ (Основы безопасности жизнедеятельности)
- Педагогика
- Полиграфия
- Психология
- Салық
- Саясаттану
- Сақтандыру
- Сертификаттау, стандарттау
- Социология, Демография
- Спорт
- Статистика
- Тілтану, Филология
- Тарихи тұлғалар
- Тау-кен ісі
- Транспорт
- Туризм
- Физика
- Философия
- Халықаралық қатынастар
- Химия
- Экология, Қоршаған ортаны қорғау
- Экономика
- Экономикалық география
- Электротехника
- Қазақстан тарихы
- Қаржы
- Құрылыс
- Құқық, Криминалистика
- Әдебиет
- Өнер, музыка
- Өнеркәсіп, Өндіріс
Қазақ тілінде жазылған рефераттар, курстық жұмыстар, дипломдық жұмыстар бойынша біздің қор #1 болып табылады.



Ақпарат
Қосымша
Email: info@stud.kz